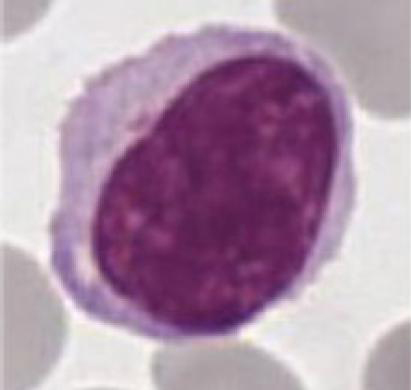

Le rôle du système immunitaire est de protéger l’organisme contre l’invasion par des microorganismes extérieurs. Chez l’homme, on retrouve des mécanismes défensifs, dénommés immunité innée, semblables à ceux que l’on observe chez des organismes moins évolués, comme les insectes. Les cellules responsables de l’immunité innée (macrophages, neutrophiles, éosinophiles…) expriment un nombre restreint de récepteurs permettant d’interagir avec des familles d’antigènes retrouvées sur différents pathogènes. A cette immunité innée, s’est rajoutée au cours de l’évolution une immunité adaptative, dont les acteurs sont les lymphocytes B et T qui expriment des récepteurs à l’antigène très diversifiés (BCR ou anticorps pour les lymphocytes B et TCR pour les lymphocytes T). Cette diversité des récepteurs permet potentiellement de reconnaître très spécifiquement l’ensemble des agents infectieux existants.
L’immunité innée et l’immunité acquise ne sont pas totalement indépendantes :elles agissent en collaboration. Les différents types cellulaires de l’immunité sont présents dans le sang et le système lymphatique (thymus, rate, ganglions lymphatiques, moelle osseuse).
La reconnaissance des microorganismes par les cellules de l’immunité s’effectue grâce à des récepteurs à l’antigène. Ces récepteurs sont des protéines de la membrane cellulaire qui ont la capacité de s’adapter à des structures protéiques ou à des polysaccharides (enchaînement de sucres comme le glucose ou le mannose), et de s’y fixer selon le modèle clé-serrure. Cette fixation entraîne une cascade d’événements moléculaires permettant de signaler à la cellule la présence du microorganisme et de déclencher une séquence programmée de réponses.
Les récepteurs de l’immunité innée sont retrouvés chez tous les individus d’une même espèce. Les gènes qui les codent font partie du patrimoine génétique de l’individu. Ces récepteurs ont été sélectionnés au cours de l’évolution pour interagir spécifiquement avec des d’antigènes exprimés par des microorganismes pathogènes. Face à une infection, un grand nombre de cellules de l’immunité innée sont donc capables de reconnaître l’agent infectieux et sont mobilisées rapidement pour y répondre.
À l’inverse, la diversité des récepteurs à l’antigène des cellules de l’immunité adaptative est acquise au cours du développement de l’individu par remaniement au hasard de leurs gènes. À l’issue de ce processus, chaque lymphocyte est armé d’un récepteur à l’antigène qui lui est propre. C’est ce que l’on dénomme la spécificité d’un lymphocyte pour un antigène. Ce remaniement génétique (recombinaisons) étant aléatoire, il conduit fréquemment à la production de lymphocytes exprimant des récepteurs capables de réagir contre des antigènes de l’organisme ou antigènes du soi (en opposition aux antigènes exogènes du non soi). Afin de prévenir la réponse du système immunitaire contre l’organisme (le soi) un processus de sélection permet de détruire les lymphocytes auto réactifs potentiellement dangereux. C’est grâce à ce processus d’apprentissage que les lymphocytes B et T sont capables de distinguer le soi du non soi.

Macrophage (en jaune) capturant des bactéries (en vert) au moyen de longues extensions appelées pseudopodes, pour les neutraliser en les absorbant (processus de phagocytose). 
Les anticorps sont de grandes protéines en forme de Y. À l’extrémité des branches du Y se trouvent les sites de fixation à l’antigène (zones marquées en jaune), responsables de la spécificité d’un anticorps pour une molécule donnée du « non soi ». Photo Wikipédia
L’immunité innée est la première ligne de défense durant la période critique qui suit l’exposition à un pathogène. Les cellules de l’immunité innée détectent des signaux provenant de pathogènes et alertent le système immunitaire. Suite à une telle reconnaissance, une réponse inflammatoire et anti-microbienne est déclenchée. Lors d’une infection, les lymphocytes B et T spécifiques de l’agent infectieux, sont activés par l’intermédiaire de leur récepteur à l’antigène. Lorsque l’agent infectieux est rencontré pour la première fois par le système immunitaire, une phase de multiplication et de maturation des lymphocytes B et T spécifiques est nécessaire avant qu’il soit en mesure de détruire l’agent pathogène et les cellules infectées. La réponse adaptative n’est donc opérationnelle que 5 jours après le début de l’infection. Lors d’une ré-exposition à cet agent infectieux, l’immunité adaptative (immunité acquise) possède la propriété remarquable de conserver une mémoire et sera en mesure de répondre plus rapidement et plus efficacement contre l’agent infectieux. C’est ainsi que la rougeole ou la varicelle contractées durant l’enfance conduisent à la protection de l’individu pour sa vie durant.
Les lymphocytes B effectuent leur maturation dans les ganglions lymphatiques et la rate. Lorsqu’ils en ressortent, chaque lymphocyte B exprime un récepteur d’antigène unique à sa surface (B cell receptor ou BCR). Lorsqu’une cellule B naïve (qui n’a jamais rencontré d’antigène) rencontre pour la première fois l’antigène pour lequel son récepteur est spécifique, la liaison BCR-antigène initie la division rapide de la cellule et provoque en même temps son adaptation. A l’issue de cette adaptation, les lymphocytes B migrent vers la moelle osseuse et se différencient en plasmocytes qui sécrètent les anticorps.
Ces anticorps rejoignent le lieu de l’infection par voie sanguine et se fixent aux agents pathogènes pour les neutraliser. Les lymphocytes T sont issus de précurseurs présents dans la moelle osseuse ayant migré dans le thymus où ils ont fait leur maturation durant les premiers mois de la vie. Ils migrent ensuite dans les ganglions. Les lymphocytes T initient l’immunité spécifique à médiation cellulaire (réponse cytotoxique) et jouent un rôle important dans la régulation de la réponse humorale (réponse anticorps). Les lymphocytes T CD4+ ont un rôle d’activation et de régulation de la réponse humorale (lymphocytes B) et cellulaire (lymphocytes T CD8+). Les lymphocytes T CD8+ ont des propriétés cytotoxiques, c’est-à-dire qu’ils ont la capacité de tuer les cellules infectées qu’ils reconnaissent grâce à leur récepteur à l’antigène (T cell receptor ou TCR). Contrairement aux anticorps qui interagissent directement avec les agents pathogènes, les récepteurs à l’antigène des lymphocytes T reconnaissent des fragments de protéines de ces agents pathogènes qui sont présentés par des molécules du CMH (complexe majeur d’histocompatibilité) des cellules infectées ou des cellules de l’immunité. Ces molécules du CMH sont des sortes de pinces moléculaires qui enserrent des fragments de protéines (peptides) et qui les transportent à la surface cellulaire pour les exposer aux lymphocytes T. Les lymphocytes T CD8+ reconnaissent les complexes formés par les peptides antigéniques et les molécules du CMH de classe I exprimées par toutes les cellules de l’organisme. Les lymphocytes T CD4+ reconnaissent les complexes formés par les peptides antigéniques et les molécules du CMH de classe II exprimées exclusivement par les cellules du système immunitaire. Ce sont les cellules dendritiques et les macrophages (CPA : cellules présentant l’antigène) qui déclenchent la réponse cellulaire en phagocytant les agents infectieux ou les débris de cellules infectées et en présentant les peptides infectieux à l’aide de leurs molécules du CMH de classe II aux lymphocytes T CD4+.

Lymphocyte B – UMR Inserm U917 
Lymphocyte T – JGT Science Photo Library